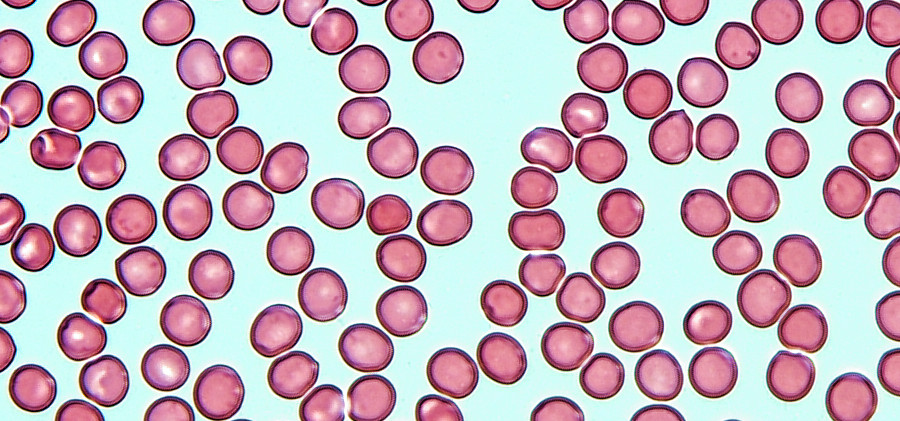

Accurate measurement of the concentration of cells in blood is important for diagnosis or therapy monitoring of many diseases. The comparability of the measurement results within a laboratory and between different laboratories is critical for patient safety. To assure comparability of the measurement methods, so-called reference measurement procedures for the determination of cell concentrations have been used at PTB for many years. Reference measurement procedures are accepted methods by which the accuracy of other measurement procedures can be determined. They are characterized by a fully detailed examination of the measurement uncertainty and consideration of all influencing quantities and interfering components. Together with clinical partners, PTB has developed a reference measurement procedure for red blood cells in blood. For many years, this method is applied for external quality assurance in Germany. Recently, it has also been accepted internationally by the Joint Committee for Traceability in Laboratory Medicine (JCTLM) (Reference measurement procedure C16RMP1at
https://www.bipm.org/jctlm/).
Publication
JCTLM Database Newsletter, 9 (2022); available online
https://www.bipm.org/jctlm/
原文源自德国联邦物理技术研究院网站,版权归其所有。如有侵权,请联系,第一时间删除。
